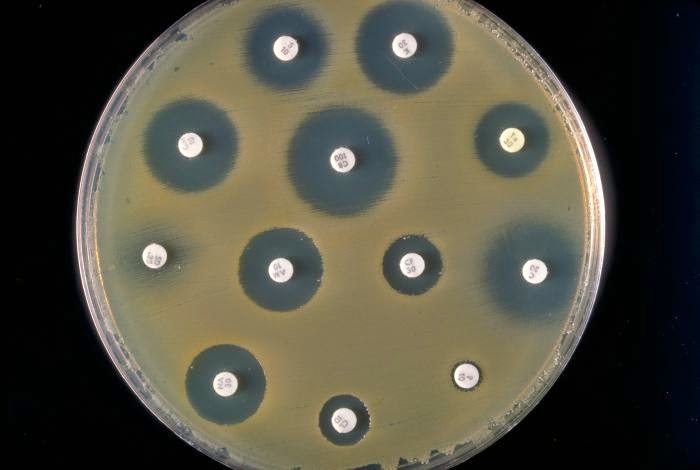

La función de los cultivos es demostrar la presencia de bacterias que, según el contexto y la presencia de síntomas, pueden indicar enfermedad (no así en la bacteriuria asintomática).
En general, los resultados de los cultivos (y en la urología, sobretodo el urocultivo o cultivo de orina) pueden ser:
*Negativos: estériles, sin presencia de bacterias.
*Contaminados: presencia de múltiples bacterias, habitualmente por contaminación de la muestra y no necesariamente por enfermedad.
*Positivos: habitualmente se consideran positivos cuando tienen >100,000 unidades formadoras de colonias (UFC), sin embargo según la forma de obtener la muestra (sondaje vesical, punción suprapúbica) y el contexto, se pueden interpretar de forma distinta.
Una vez que se cuenta con un resultado positivo, se suelen aportar 3 datos importantes:
– La bacteria especifica
– El número de unidades formadoras de colonias
– El antibiograma (sensibilidad a antibióticos).
El antibiograma históricamente determinaba las sensibilidades con la técnica de Kirby-Bauer (ver imagen 1) que utilizaba discos impregnados de antibiótico y según el halo que se formaba a su alrededor se determinaba si la bacteria era sensible, intermedia o resistente a dicho antibiótico.
Múltiples métodos distintos se han desarrollado posteriormente.
¿Qué es la concentración mínima inhibitoria (CMI/MIC)?
Como se observa en la tabla 1 a continuación, los cultivos suelen proporcionar una lista de antibióticos considerados de elección para esa bacteria en particular, una categoría de sensibilidad a dicho antibiótico (sensible, intermedio o resistente) y la concentración mínima inhibitoria (CMI) o MIC por sus siglas en inglés (mínimum inhibitory concentration).

Siempre es tentador pensar que el antibiótico con la menor CMI/MIC será la mejor elección, ya que lo intuitivo sería pensar que aquel antibiótico que requiera una menor concentración será más efectivo para eliminar dicha bacteria, cierto?
Desgraciadamente no es tan sencillo, existen múltiples factores que intervienen, como la farmacodinamia/farmacocinética de los antibióticos (efectos del fármaco en el cuerpo y su metabolismo por el organismo), la concentración en el lugar de la infección (algunos fármacos se acumulan más en hueso, tejidos blandos, sistema urinario, etc.), el tiempo que se mantienen las concentraciones por encima de la CMI/MIC, la ruta que se piensa utilizar (oral, intravenosa, intramuscular) y la susceptibilidad propia de la bacteria a dicho antibiótico (algunas bacterias son particularmente sensibles a algunos antibióticos).
Cabe señalar que el punto de corte y el rango de diluciones difieren según el fármaco (ver Imagen 2) y la especie bacteriana. Por lo tanto, comparar las CMI/MIC de diferentes antibióticos no se basa únicamente en el valor numérico, por lo que una menor CMI/MIC no es necesariamente mejor que otro antibiótico con una CMI/MIC superior.

Un resultado «intermedio» indica que un microorganismo cae en un rango de susceptibilidad en el que la CMI/MIC se acerca o excede el nivel de antibiótico que puede alcanzarse normalmente y para el cual la respuesta clínica es probable que sea menor que con una cepa susceptible. Pueden ocurrir excepciones si el antibiótico está altamente concentrado en un fluido corporal como la orina con la Nitrofurantoina por ejemplo, o si se pueden administrar con seguridad dosis más altas de lo normal del antibiótico (p. Ej., Algunas penicilinas y cefalosporinas).
Take-home message:
- Las concentraciones mínimas inhibitorias no deben interpretarse entre antibióticos ya que no son comparables, múltiples variables intervienen en su interpretación y generalmente se requiere de un amplio conocimiento de farmacocinética y farmacodinamia de antibióticos y susceptibilidad bacteriana intrínseca para poder distinguir la mejor opción.
- No se debe elegir entre un antibiótico u otro solamente basados en la CMI/MIC ya que el punto de corte varía según cada antibiótico y no son extrapolables.
Referencias
- Jorgensen JH, Ferraro MJ. Antimicrobial susceptibility testing: a review of general principles and contemporary practices. Clin Infect Dis. 2009;49(11):1749‐1755. doi:10.1086/647952
- Jorgensen JH, Ferraro MJ. Antimicrobial susceptibility testing: general principles and contemporary practices. Clin Infect Dis. 1998;26(4):973‐980. doi:10.1086/513938
- Should I Choose the Antibiotic With the Lowest MIC?. Michael J. Postelnick, BSPharm. August 14, 2009. Accessed: May 31, 2020. [ URL: https://www.medscape.com/viewarticle/707223 ]